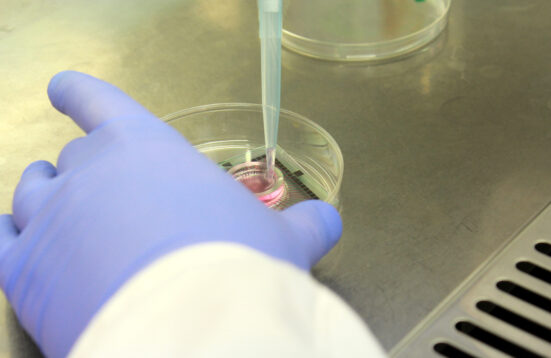

event | Talk, Talk
event | Talk, Talk
- A project by
- Tessa Zettel and Sumugan Sivanesan
28 June 2015
With Plan Bienen the artists attempt to make real and speculative connections between two parallel crises – one within European economic systems and the other in honeybee ecologies. Considering Berlin’s development as a multicultural ‘creative’ capital…
 event | Talk
event | Talk
- with Berlin iGEM team
31 January 2016
The iGEM Berlin team (http://igem.berlin/) presents their fourth SciArt Café. Under the main theme of “Programming Life – Good Code/ Bad Code?” we will hear scientists and artists working with bioscience and afterwards discuss topics of synthetic biology.
Read More
 event | Performance, Talk
event | Performance, Talk
- 1000 Handshakes
- François-Joseph Lapointe
3 / 5 February 2016
As part of the opening of the 2016 transmediale festival of art & digital culture at Haus der Kulturen der Welt, Art Laboratory Berlin will present the performance 1000 Handshakes by and with François-Joseph Lapointe.
Read More
 event | Talk
event | Talk
- Human Impact on the environmentally sensitive Galapagos and Lord Howe Islands
- Lea Kannar-Lichtenberger
22 May 2016
In the Age of the Anthropocene, this talk will explore how humans impact on our world both by their presence and indirectly by their lifestyle. This is a science-art investigation of tourism and its effects on closed eco systems.
Read More
 event | Talk
event | Talk
- Interdisciplinary Dialogs in the Sciences and Humanities
- Antonia Ulrich and Marie Neuwald
17 July 2016
For the closing event of the exhibition On Animals. Cognition, Senses, Play we are pleased to invite you to an interdisciplinary dialog with philosopher Antonia Ulrich and Marie Neuwald from NABU.
Read More
 event | Course, Meet up, Talk, Workshop
event | Course, Meet up, Talk, Workshop
- with Biotinkering e.V.
- Dr. Mirela Alister, Rüdiger Trojok, Alessandro Volpato and Biotinkering e.V.
25 August 2016 - 20 April 2017
The Bio & Beers format is for everyone: we start with a 20 minutes presentation, followed by discussions while having beers. In addition there will be occasional DIY workshops!
Read More
 event | Conference, Talk
event | Conference, Talk
- Living Systems | Aquatic Systems
- Robertina Šebjanič, Kat Austen, Regine Rapp and Christian de Lutz
18 September 2016
In this seminar we want to invite you to theoretically explore these and other aspects about artistic and scientific methodologies on interspecies empathy and human-nonhuman companionship.
Read More
 event | Talk
event | Talk
- with BIOMOD and iGEM Team Berlin
29 January 2017
The iGEM Berlin team (http://igem.berlin/) presents their fifth SciArt Café. Under the main theme of “Synthetic Biology – a toolkit for solving humanity’s problems” we will hear scientists and artists working with bioscience and afterwards discuss topics of synthetic biology.
Read More
 event | Talk, Workshop
event | Talk, Workshop
- DIYBio faire
- Biotinkering e.V.
17 - 19 February 2017
The three-day bio-fair brings together the players in the Berlin biohacking scene for a series of hands-on workshops, talks and a special exhibition featuring unique DIY laboratory equipment.
Read More
 event | Performance, Talk
event | Performance, Talk
- Technosphärenklänge #3
- Guy Ben-Ary
- Presse Feedback
12 - 13 May 2017
In the work cellF human neurons living in a Petri dish perform duets with human musicians: These are grown into a culture of 100,000 living neurons. Lined with electrodes, these neurons form output via an analog synthesizer, cellF, allowing them to “jam” with human musicians.
Read More
 event | Talk
event | Talk
- Artist Talk
5 May 2017
In his talk Guy Ben-Ary will present some of the methodologies and theories that underpin his artistic practice by using as examples, four of his major projects completed over the last decade: MEART, The Silent Barrage, In-Potentia, and CellF
Read More
 event | Performance, Talk, Workshop
event | Performance, Talk, Workshop
- Gut Feelings
- Alanna Lynch
18 June 2017
Alanna Lynch has been growing the microorganisms that produce kombucha tea. Through the process of fermentation this symbiotic colony of bacteria and yeasts (SCOBY) produces a cellulose material that is slimy and smells strongly while wet and can be dried and used as a textile.
Read More
 event | Performance, Talk, Workshop
event | Performance, Talk, Workshop
- Anatomy of an inter-connected system
- Margherita Pevere
15 July 2017
Starting point is the artist’s research at the junction of visual arts, theoretical inquiry and investigation of biological processes, focusing on the discourses regarding human-nature relationship in the frame of today’s environmental crisis and how artistic practices…
Read More
 event | Talk
event | Talk
- ill-at-ease seep
- Sarah Hermanutz
28 October 2017
In her lecture the artist Sarah Hermanutz discussed the relationship between humans and wetlands, which is the focus in her long-term artistic research. Wetlands are one of the most biologically diverse and important ecosystems for life on earth, but within the past century..
Read More
 event | Performance, Talk
event | Performance, Talk
- Bidisha Das and Thomas Heidtmann
3 - 5 August 2018
is an interactive installation that spans a visual and acoustic connection between outer space and physical spaces that surround us. It is an orchestra of movement using elements from outer space, nature and human bodies as instrumentations.
Read More